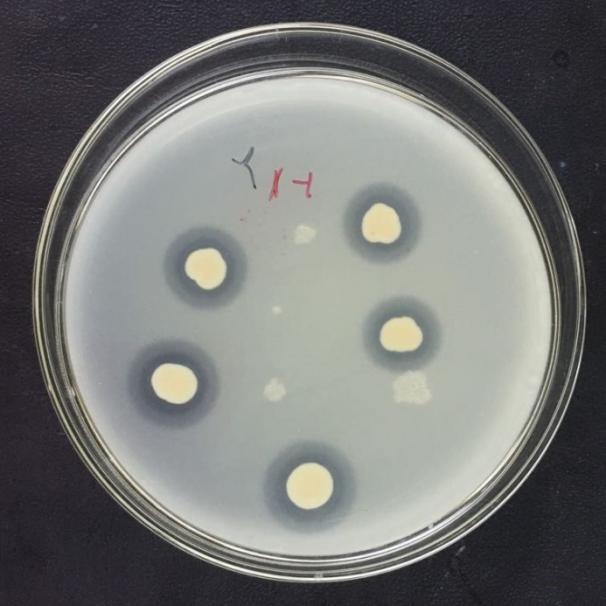

成果简介
该成果属于林木培育及功能微生物开发利用领域。广西人工林面积全国第一,是全国速生丰产林基地、国家战略储备林核心基地,但人工林生产力还有很大的提升潜力。在国家自然科学基金、林业科技推广项目等资助下,针对目前林地养分失衡、幼苗幼树生长缓慢的问题,挖掘林地土壤功能菌,创新林木培育技术。从林木根际分离、筛选的解磷菌在温度为35℃、pH为7.5、碳源为葡萄糖、氮源为硫酸铵、C/N为40:1、盐浓度为1.5%时解无机磷效果最好,能够分泌磷酸酶和植酸酶以溶解难溶性有机磷,并分泌植物激素和铁载体,促进植物光合作用、呼吸作用、物质和能量代谢,可用于解决林木根系发育迟缓、幼苗生长缓慢的问题,苗木生长量提高20%以上。
应用前景
该菌株可将难溶性的有机磷和无机磷转化为能够被植物吸收的有效磷,解决幼苗树树根系发育迟缓、生长缓慢的问题。已实现稳定分离、筛选、培养,技术可靠,可用于研发微生物菌剂、开发有机无机微生物混合肥料,提高林木生长量。
成熟度
已分离、筛选的菌株保藏于中国微生物菌种保藏中心管理委员会普通微生物中心。该菌株已经通过特殊的改良菌液制备成菌液菌剂,并正在开展育苗盆栽接种实验,处于小试阶段,有望通过在育苗和幼树栽培上的成功应用,进一步大规模生产应用推广。
成果展示
图1 有机磷解磷圈 图2 无机磷解磷圈

|

|
图3 唐菖蒲伯克霍尔德菌P8在盆栽苗木上的应用 |
知识产权情况
序号 |
专利号 |
成果名称 |
1 |
ZL 202111531315.5 |
一株唐菖蒲伯克霍尔德菌P8及其应用 |
2 |
ZL 202111533218.x |
一株蜡样芽孢杆菌P1及其应用 |
成果完成人
林学院:杨梅
成果转化,请联系成果与合作处,联系人:王老师,联系电话:0771-3810467。